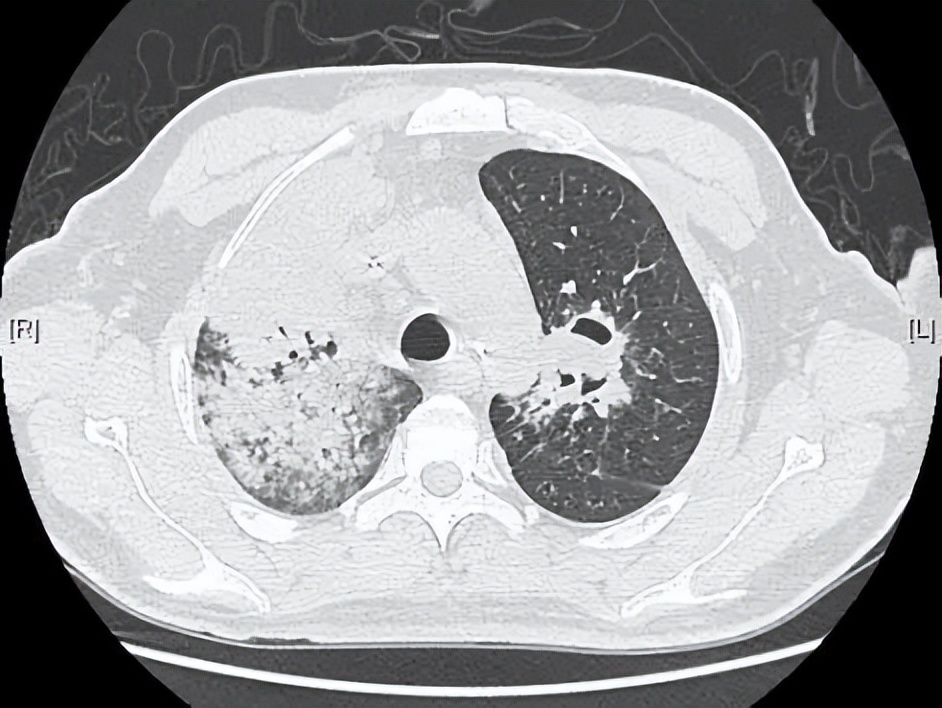
病死率和致死率,病死率20%

引言
毛霉菌感染,正如文章标题所言,在呼吸领域「谈之色变」,因其病死率极高,诊治极困难,因而诊断和治疗丝毫不得马虎。该病例患者的左肺上叶、右肺上叶、中叶、下叶均有受累,手术切除范围极大,因此也是外科手术治疗的禁忌症,在治疗过程中应该采取哪些措施?有什么办法能使患者好转快、副作用少、花费低?近期我们成功治愈了多例这类患者,是如何做到让患者病死率目前为0,无1例出现死亡,且预后效果极佳的?本次选取其中一个案例,希望能给同道一些启示。
49岁男性因咳嗽咳痰、咯血诊断为肺部重症感染、糖尿病酮症酸中毒……1个月辗转数家医院治疗无效,病情持续进展
这是一名来自于河北省的49岁男性患者,因「咳嗽、咳痰、咯血」就诊当地医院,诊断为肺部重症感染、糖尿病酮症酸中毒。既往糖尿病20余年,未规律诊治。1个多月期间,患者辗转河北数家医院,先后给予抗细菌、抗结核等治疗均无效。病情持续进展,双肺出现播散性病变,病变累及双上肺及双下肺(图1)。

图1:外院胸部CT显示双肺多发病变,双上肺病变为主,局部病灶伴有空洞。
1个月前,患者就诊于北京某三甲医院,诊断为肺毛霉病,立刻给予两性霉素B脂质体硫酸酯复合物(300mg/天)联合泊沙康唑(300mg/天)静脉治疗的方案。但经过足量治疗1个月,症状依然无好转,待到来我院就诊时,肺内病变继续进展,胸部CT可见左肺上叶、右肺上叶、中叶、下叶毛霉菌感染扩散,患者本人也出现了精神萎靡,食欲下降,咯血加重,体重下降20kg。
思考题: 为什么使用两性霉素B脂质体等联合治疗无效?下一步应该采取哪些检验措施?
患者入院后查胸部CT可见:左肺上叶、右肺上叶、中叶、下叶多发斑片和片状渗出实变影(图2)。血气分析显示为Ⅰ型呼吸衰竭。完善肿瘤标志物、呼吸道病原九项、真菌D-葡聚糖检测、真菌GM实验、结核杆菌抗体试验未见明显异常,多次痰培养阴性。

图2:入院胸部CT可见肺内多发斑片和片状肺内渗出实变影,右上肺大片实变影伴空洞,左上肺可见真菌球。
患者入院后,于2022年4月18日行电子支气管镜检查提示:气道下段息肉、右肺上叶前段白色粘稠分泌物完全阻塞气道,左肺上叶尖段白色粘稠分泌物(图3)。

图3(左):右肺上叶支气管;图4(右):左肺上叶尖段:气管镜下可见毛霉菌坏死物质堵塞气道
支气管镜活检组织病理显示组织炎性坏死,其内见无隔菌丝,菌丝粗大,排列杂乱,可见直角分枝,形态符合毛霉菌。特殊染色PAS(+)、六胺银(+)、抗酸(-)。病理组织宏基因组二代基因测序 (mNGS) 显示为戴尔根霉。最终确定诊断为播散性肺毛霉病。

图5-6:病理显示坏死组织内大量毛霉菌菌丝
明确诊断后,团队很快进行了包括血管介入科、胸外科、检验科、影像科及病理科等多学科MDT讨论。外科考虑患者为双肺播散性病灶无法行外科手术治疗。因此根据患者的病理诊断及NGS测序结果,在两性霉素B脂质体硫酸酯复合物(300mg/天)联合泊沙康唑(300mg/天)静脉全身治疗的同时,予两性霉素B 10mg bid雾化吸入治疗。同时经导航和超声支气管镜定位下每周局部精准灌注两性霉素。并在多种预处理及预置措施下,经支气管镜下冷冻治疗冻取完全清除右侧支气管内病灶(图5);通过支气管镜介入治疗的办法将左上肺尖段的肺真菌球也完全取出(图6)。并针对患者的基础病予以对症降糖等治疗。治疗期间,患者出现了低钾血症,应用补钾药物及保钾利尿剂后血钾保持在正常水平。

图7(左):右肺;图8(右):左肺,应用冷冻等支气管镜介入治疗取出的支气管肺病变。
经过大约1个半月的治疗,复查胸部CT显示肺部病变较前几乎完全吸收好转(图5)。出院后继续口服泊沙康唑片剂,定期门诊随诊。
图9:入院时胸部CT

图10:出院时胸部CT:间隔41天
随着免疫功能低下患者增多,肺毛霉菌病发病率也逐渐增加。一旦患者出现双肺或全身播散性病变,其病死率可高达80-100%
谈到毛霉菌的病死率极高,首先就要了解毛霉菌。毛霉菌既往称接合菌,普遍存在于自然界,可见于腐烂植被和土壤中,居家环境中的地下室、洗手间和厨房等阴暗潮湿处也经常可见。包括根霉属,毛霉属,犁头霉属和被孢霉属。前两者更常见。
肺毛霉菌病以前称接合菌病,是毛霉目真菌引起的一类条件致病性真菌病,肺毛霉菌病主要感染途径是空气中的孢子吸入,其他途径还包括直接摄入和皮肤接触。肺毛霉菌病主要影响免疫功能低下患者,如恶性肿瘤患者,糖尿病患者,器官移植患者等免疫*制剂抑**使用人群等。随着免疫功能低下患者的增多,肺毛霉菌病发病率也在逐渐增加。因此,一旦患者出现双肺或全身播散性病变,其病死率可高达80-100%。
一直以来,毛霉菌的诊治极困难,在整个呼吸领域里都是「谈之色变」。毛霉菌病的标准管理措施包括:早期诊断,逆转危险因素和潜在疾病,手术清创和及时静脉应用抗真菌药物。治疗方面,它的首选药物通常是两性霉素B或者两性霉素B脂质体。同时,需要及时处理高血糖、酸中毒,并尽可能停止应用免疫*制剂抑**。
由于肺毛霉菌病可以引起血管阻塞,静脉常规使用肺毛霉病治疗药物难以渗入病灶,故单用静脉/口服抗真菌药物治疗效果差。除了静脉应用之外,同时采用两性霉素B雾化吸入、气管镜下介入清创联合两性霉素B局部灌注治疗,为肺毛霉病患者转归提供有益帮助,这也是我们团队首创的综合疗法,是海陆空+精确制导*器武**的立体协同作战(海:静脉注射,陆:支气管镜直接介入清创病灶,空:雾化吸入药物,精确制导:通过导航和超声支气管镜精准药物灌注)。当然我们还有最后一招就是原*弹子**(外科手术切除病灶),但不首先使用。
我们知道,该病例患者的左肺上叶、右肺上叶、中叶、下叶均有受累,手术切除范围极大,因此也是外科手术治疗的禁忌症。而面对凶险的毛霉菌感染,致死率如此之高,如何在治疗过程中跟病情的发展抢时间,关键在于治疗的手段和用药上。我们在治疗过程中给予了静脉两性霉素B硫酸胆固醇脂质体复合物+静脉泊沙康唑+雾化吸入两性霉素B+气管镜下冷冻治疗+支气管镜下局部灌注两性霉素B。对于如此凶险的毛霉菌感染,我们的治疗类似鸡尾酒疗法,联合使用药物,以此减少治疗时间以及副作用。也是海陆空+精确制导*器武**的多军种立体协同作战的效果。
雾化吸入两性霉素B可以一天两次使用,不经血液直达肺部,效果更好且副作用更小。但是雾化吸入两性霉素B容易出现气道高反应,使用期间需要加强患者症状的观察和肺部听诊,必要时预处理或停药。静脉两性霉素B及其脂质体、泊沙康唑、艾莎康唑等是目前毛霉菌治疗的首选药物,病情严重者建议联合治疗。
我们采取了多途径联合用药再联合支气管镜介入清创的方法,这样可以使患者好转快、副作用少、花费低,效果极佳。毛霉菌容易侵犯支气管和血管,传统的风险极高。随着对疾病认识的深入以及支气管镜介入治疗技术的提高,我们在全身联合治疗和局部雾化治疗的基础上,采取全身麻醉+气管插管+预置球囊、预先灌注,灵活操作、注意手法、小心谨慎,循序渐进的方法,取得了非常好的效果。
参考文献
[1] 张会娟,牟向东,尹洪芳,赵景全,宛莹华,郭文佳.经导航支气管镜局部灌注两性霉素B治愈肺毛霉病一例[J].中华结核和呼吸杂志,2021,44(8):733-735.
[2] 周沛宁, 牟向东, 王茫桔, 等. 累及胸壁和肋骨的肺毛霉病[J] . 中华结核和呼吸杂志,2019,42( 1 ): 71-72.
[3] 牟向东, 王广发, 刁小莉等.肺毛霉菌病三例临床分析. 中华结核和呼吸杂志,2007, 30(11): 835-838.
[4] Mu XD, Wang GF. Bronchopulmonary zygomycosis. Respiration. 2011; 82(4):386-7. PMID: 21734349
[5] 牟向东. 接合菌病的诊断和治疗现状. 实用皮肤病学杂志, 2011,4(4): 193-197.
[6] 牟向东. 肺毛霉菌病的诊断和治疗. 中国社区医师杂志, 2008, 24(8): 13.
[7] 牟向东, 许西琳. 是肺曲霉病, 还是肺毛霉病?中华结核和呼吸杂志, 2015, 38(07): 234-235.
[8] 牟向东, 龙爽. 侵袭性肺部真菌感染的诊断. 临床内科杂志, 2016, 33 (12): 801-803.[9] 牟向东, 黄珺君, 林钢, 等. 支气管肺空洞瘘合并真菌感染临床分析. 中华医学杂志, 2018, 98(12): 948-950.
专家介绍

牟向东
清华大学附属北京清华长庚医院呼吸与危重医学科主任,主任医师、教授,硕士研究生导师。2005年于北京大学医学部获得博士学位。北京医学会呼吸病学分会青年委员会第一届副主任委员,中华医学会呼吸病学分会第十届青年委员会委员,中华医学会呼吸病学分会感染学组委员。伍连德连德基金会呼吸专委会支扩学组组长。中国医药教育协会肺癌医学教育委员会委员,北京医学教育协会呼吸学组专科分会委员,北京整合医学学会介入诊疗转化医学分会常务委员。中华医学杂志/&英文版、中华结核和呼吸杂志通讯编委和审稿专家。Thorax中文版感染专刊编委。在国内外医学期刊第一作者发表论文100余篇,其中在NEJM发表3篇,2016年荣获“首都十大杰出青年医生”称号。

李理
清华大学附属北京清华长庚医院呼吸与危重症医学科主治医师。2012年于首都医科大学获得硕士学位。擅⻓呼吸科常⻅疾病诊治,熟练气管镜操作。学术任职:北京市昌平区医学会,呼吸病学分会委员。
* 文章仅供医疗卫生相关从业者阅读参考
本文完
采写编辑:冬雪凝;责编:Jerry